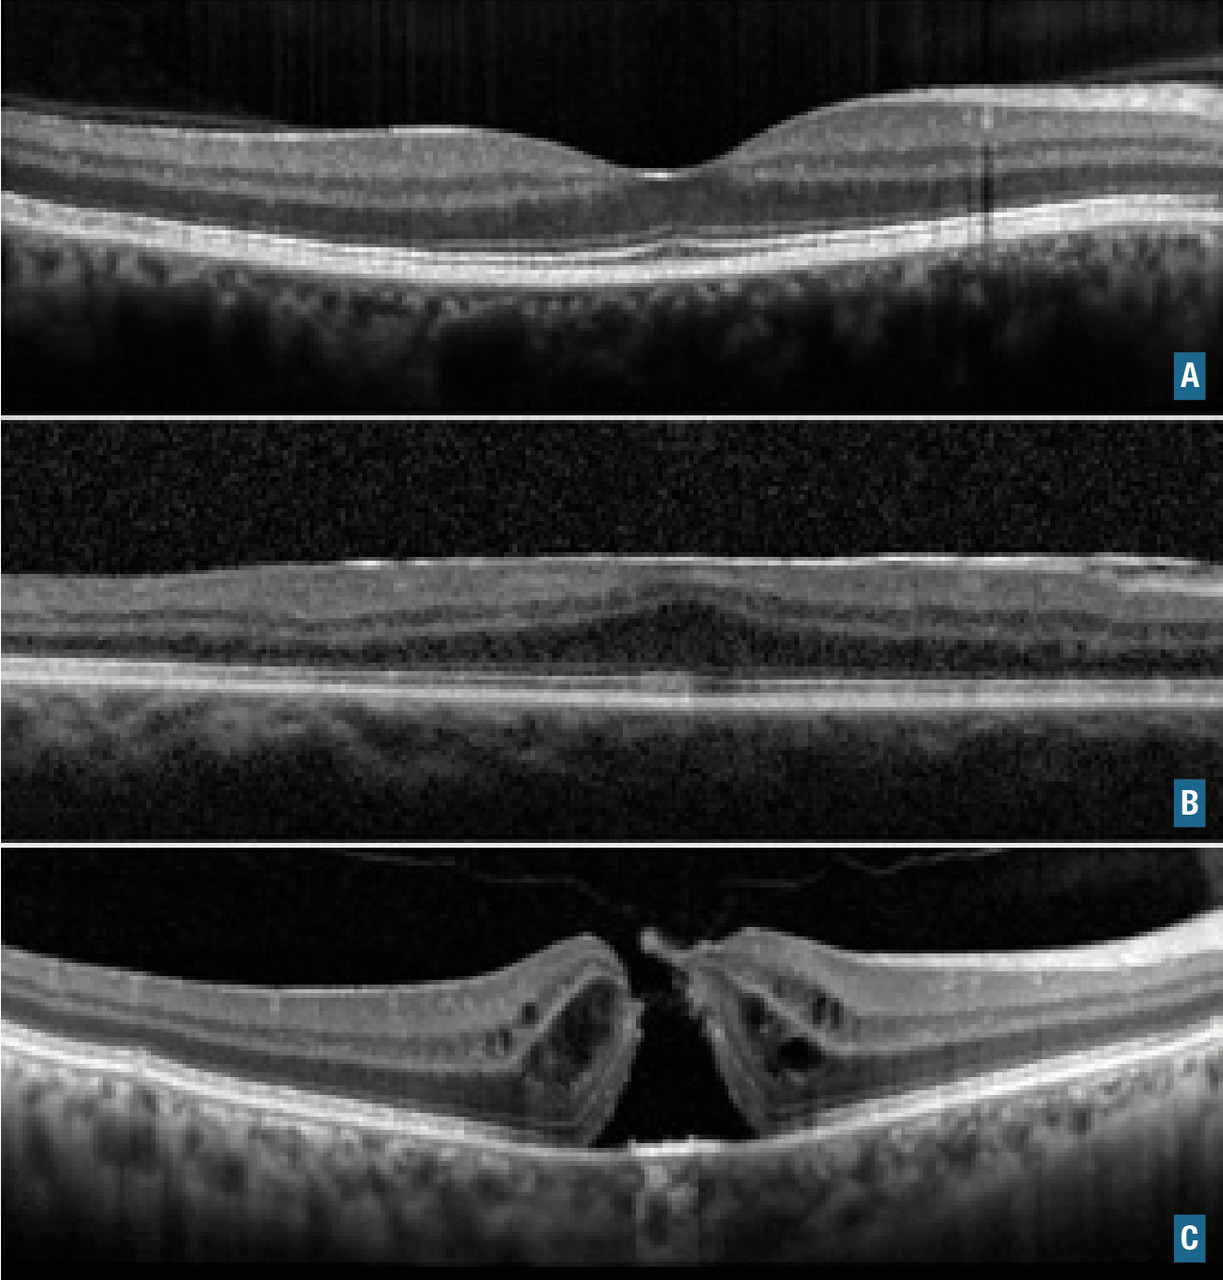
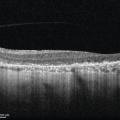

Connaître les principales étiologies d’altération chronique de la vision et les examens complémentaires pertinents.
Examen
Interrogatoire
- préciser le type d’altération visuelle :
- une baisse objective de l’acuité visuelle fait explorer l’intégrité et le fonctionnement des structures dans l’axe visuel, donc la vision centrale,
- une altération du champ visuel : dépistée grossièrement au doigt, elle est objectivée par l’examen périmétrique qui met en évidence un déficit de sensibilité. Ce déficit peut être central ou périphérique, unilatéral (scotome) ou bilatéral, avec respect du méridien vertical (quadra- ou hémianopsies) ou non ;
- préciser les symptômes associés :
- des métamorphopsies (ondulation des lignes droites) pouvant être dépistées par la grille d’Amsler, elles orientent vers une atteinte maculaire,
- des macropsies ou micropsies (impression de grossissement ou de rétrécissement des images),
- une dyschromatopsie (modification de la vision des couleurs) pouvant être objectivée par un test de la vision des couleurs,
- une photophobie (éblouissement),
- une diminution de la sensibilité aux contrastes,
- la présence de myodésopsies (visualisation de « mouches volantes » orientant vers une pathologie vitréenne),
- de phosphènes (éclairs lumineux orientant vers une atteinte rétinienne et en particulier une déchirure ou un décollement de rétine),
- une éclipse visuelle brève (disparition totale de la vision, quelques secondes, souvent bilatérale, déclenchée par les mouvements de la tête ou les efforts),
- une cécité monoculaire transitoire (disparition unilatérale totale de la vision, plus ou moins sombre, pendant quelques minutes à une heure, spontanément résolutive), orientant vers une cause neurologique vasculaire,
- une aura visuelle (scotome scintillant en règle bilatéral, s’étendant progressivement à partir de la périphérie sur le champ visuel, précédant ou non une céphalée migraineuse) ;
- déterminer son mode d’installation : ces symptômes sont apparus brutalement ou progressivement sur plusieurs heures/jours/semaines ;
- définir son caractère uni- ou bilatéral ;
- préciser la présence ou non de douleurs associées et leur type :
- douleurs superficielles, évoquant une affection du segment antérieur (kératite, corps étranger cornéen...), plus ou moins soulagées par la fermeture palpébrale,
- douleurs profondes, avec céphalées irradiant dans le trajet du nerf trijumeau faisant évoquer une hypertonie oculaire. Elles peuvent être associées à des nausées dans le cas de pression intraoculaire très élevée, pouvant faire évoquer une crise de glaucome aigu,
- céphalées « vraies », pulsatiles ou non, évoquant une cause neurologique ;
- rechercher des antécédents oculaires et généraux ;
- préciser les traitements oculaires et généraux en cours ou récemment arrêtés.
Examen ophtalmologique
- la mesure de l’acuité visuelle de loin et de près, avec correction optique si nécessaire ;
- la mesure du tonus oculaire ;
- la réactivité pupillaire : réflexe photomoteur direct et réflexe photomoteur consensuel à l’éclairement de l’œil controlatéral avec recherche d’un déficit pupillaire afférent relatif du côté de la baisse visuelle si l’on s’oriente vers une cause neuro-ophtalmologique ;
- l’examen du segment antérieur au biomicroscope : cornée, chambre antérieure et cristallin ;
- l’examen après dilatation pupillaire : cristallin, vitré, rétine, vaisseaux rétiniens, nerf optique.
Examens complémentaires
Les examens complémentaires strictement « ophtalmologiques » (optical coherence tomography [OCT], champ visuel [manuel, Goldmann, ou automatisé], topographie cornéenne, angiographies rétiniennes, électrorétinogramme [ERG], potentiels évoqués visuels [PEV]...) peuvent être associés à des examens complémentaires systémiques (biologie, radiographies, imagerie orbito-cérébrale...).
À l’issue de l’examen complet initial, l’altération de la fonction visuelle peut apparaître comme « brutale » ou « progressive ». On traitera dans ce chapitre les altérations progressives de la fonction visuelle.
Anomalies du champ visuel
Atteinte unilatérale : en règle en avant du chiasma
Atteinte de la rétine
L’atteinte peut être centrale (macula), elle est alors responsable d’un scotome central avec baisse de l’acuité visuelle constante. Il s’agit par exemple de la dégénérescence maculaire liée à l’âge (DMLA) ou de l’œdème maculaire diabétique (Les pathologies rétiniennes localisées sont responsables de déficits du champ visuel siégeant dans l’hémichamp opposé. Ainsi, un décollement de rétine temporal supérieur est responsable d’un déficit campimétrique nasal inférieur.
Atteinte du nerf optique
Une atteinte complète du nerf optique entraîne une cécité unilatérale homolatérale, c’est le cas des glaucomes au stade terminal. Le glaucome est la neuropathie optique la plus fréquente ; le diagnostic est fondé sur différents examens, incluant celui de la papille, la mesure de la pression intraoculaire, la pachymétrie (mesure de l’épaisseur cornéenne), la gonioscopie (étude de l’angle iridocornéen), l’OCT pRNFL (mesure de l’épaisseur péripapillaire [p] de la couche [Layer] des fibres nerveuses ganglionnaires rétiniennes) et le type de déficit du champ visuel. L’atteinte du nerf optique peut être responsable d’un déficit diffus ou localisé : scotome central (dit aussi cæcocentral s’il rejoint la tache aveugle), mais aussi fasciculaire.La neuropathie optique éthylique peut entraîner un scotome cæcocentral bilatéral tout comme les autres causes toxiques (éthambutol, isoniazide, méthanol) avec typiquement une dyschromatopsie.
La neuropathie optique héréditaire de Leber et l’atrophie optique dominante sont les deux principales formes d’atrophie optique d’origine génétique. Ces pathologies se présentent comme une baisse d’acuité visuelle rapide ou progressive avec atrophie du nerf optique, scotome cæcocentral et dyschromatopsie.
Il est important de ne pas méconnaître les causes tumorales, qui peuvent donner tous les types de déficit, une imagerie par résonance magnétique (IRM) est systématiquement demandée en cas d’atteinte inexpliquée du nerf optique, à la recherche d’une cause tumorale (méningiome surtout, gliome).
Les névrites optiques ou neuropathies optiques inflammatoires donnent un tableau de baisse visuelle douloureuse rapidement progressive, et l’altération du champ visuel est variable. Leurs séquelles peuvent être responsables d’altération visuelle chronique.
En cas d’atteinte en dehors du faisceau maculaire, le patient développe un déficit arciforme fasciculaire pouvant aller jusqu’à l’atteinte d’un hémichamp supérieur ou inférieur, comme dans le cas des neuropathies optiques ischémiques antérieure aiguës (NOIAA), qu’elles soient artéritiques (Horton) ou non artéritiques vasculaires.
Atteinte bilatérale : principalement chiasma et en arrière du chiasma
Atteinte du chiasma optique
Le syndrome chiasmatique donne classiquement une quadranopsie bitemporale supérieure évoluant vers une hémianopsie bitemporale. Les causes sont dominées par les tumeurs hypophysaires, dont l’adénome hypophysaire et plus rarement le craniopharyngiome ou un méningiome (Atteinte des bandelettes optiques
Le diagnostic est évoqué devant une hémianopsie latérale homonyme, controlatérale à la lésion. Les atteintes sont rares et les causes sont vasculaires en cas d’accident vasculaire cérébral (AVC) [début brutal], tumorales (début progressif) ou traumatiques.Atteintes des radiations optiques
Elles entraînent une quadranopsie (voire hémianopsie) latérale homonyme et opposée à la lésion. Par exemple, une atteinte de la radiation inférieure (temporale) droite est responsable d’une quadranopsie supérieure gauche et une atteinte supérieure (pariétale) d’une quadranopsie inférieure controlatérale. Les causes sont les mêmes que dans le cadre des atteintes des bandelettes optiques (Atteinte du cortex visuel
Les atteintes occipitales sont responsables d’hémianopsie latérale homonyme « à couper au couteau » controlatérale à la lésion (Principales causes de baisse d’acuité visuelle progressive (fig. 6)
Amétropie – Troubles de la réfraction
Pathologies cornéennes
Les dystrophies cornéennes regroupent les pathologies cornéennes chroniques, essentiellement d’origine génétique. La plus fréquente reste la dystrophie de Fuchs.
Cataracte
Le diagnostic est clinique (lampe à fente) et se fait après dilatation pupillaire, il objective une opacification de la lentille cristallinienne. Il existe différentes formes : nucléaire, corticale et sous-capsulaire postérieure.
La principale cause est l’âge – cataracte « sénile ». Les autres causes sont notamment diabétiques, iatrogéniques (corticoïdes) et traumatiques.
La prise en charge thérapeutique est chirurgicale, en réalisant une extraction extracapsulaire du cristallin par phakoémulsification et mise en place d’un implant dans le sac capsulaire.
Glaucome chronique à angle ouvert
Cette pathologie entraîne une atteinte progressive du nerf optique parfois bilatérale et par conséquent une altération progressive du champ visuel, le plus souvent arciforme. La baisse d’acuité visuelle est tardive car le point de fixation est longtemps préservé. Le dépistage est donc capital. Le diagnostic repose sur une triade : l’hypertonie oculaire (statistiquement anormale si > 21 mmHg), l’altération du champ visuel et l’excavation clinique à grand axe vertical de la papille – rapport cup/disc ≥ 0,3 (
La prise en charge thérapeutique peut être médicale (collyres hypotonisants ou trabéculoplastie au laser) ou chirurgicale (sclérectomie profonde, trabéculectomie et plus récemment implants de type drains).
Maladies rétiniennes
Dégénérescence maculaire liée à l’âge (DMLA)
Il s’agit de la première cause de malvoyance du sujet âgé de plus de 50 ans dans les pays développés.Elle est le plus souvent bilatérale et peut être asymétrique.
Les principaux facteurs de risque sont l’âge, la génétique, l’origine ethnique (européenne), le tabac, le soleil et un régime pauvre en oméga 3.
Il existe différentes formes cliniques.
Maculopathie liée à l’âge (MLA) – ou forme précoce
Le diagnostic est fait au fond d’œil et sur l’OCT où des dépôts lipidiques – appelés drusen – (
La prise en charge consiste en une autosurveillance sur la grille d’Amsler.
DMLA de type atrophique – forme tardive sèche
Le diagnostic est fait au fond d’œil et confirmé à l’OCT où l’on constate une atrophie des couches externes de la rétine correspondant aux photorécepteurs ainsi qu’une atrophie de l’épithélium pigmentaire.
Il n’existe actuellement pas de traitement pour cette forme, et la prise en charge se limite à une surveillance régulière car elle peut se compliquer d’une forme néovasculaire. Une « rééducation basse vision » peut être proposée.
DMLA néovasculaire – forme tardive humide
Le diagnostic est le plus souvent posé par l’OCT, avec la présence d’un néovaisseau choroïdien sous rétinien et une activité exsudative avec décollement séreux rétinien. La présence du néovaisseau est initialement confirmée par l’angiographie (fluorescéine ou indocyanine) et l'OCT-angiographie selon le type de néovaisseau (
La prise en charge thérapeutique consiste en des injections intravitréennes (IVT) répétées d’anti-VEGF (vascular endothelial growth factor) à un rythme déterminé par un protocole choisi. La première doit être réalisée dans les sept jours suivant le diagnostic.
La myopie forte est une autre cause de néovaisseau. Le traitement repose également sur les IVT d’anti-VEGF.
Œdème maculaire
L’œdème maculaire est une cause fréquente de baisse d’acuité visuelle progressive (Le diagnostic est fait grâce à l’OCT, qui montre un épaississement maculaire avec des logettes intrarétiniennes ou du liquide sous-rétinien. Lorsqu’il est important, une image en « pétales de fleur » peut être visible au fond d’œil.
Les principales causes sont :
- la maculopathie diabétique. Le traitement repose sur des injections intravitréennes d’anti-VEGF ou de corticoïdes ; il s’agit aussi d’équilibrer le diabète ;
- l’occlusion de la veine centrale de la rétine ou d’une branche de veine. Elle est associée à des hémorragies rétiniennes et une tortuosité veineuse ;
- le syndrome d’Irvine-Gass ou œdème maculaire inflammatoire post-chirurgie de la cataracte ;
- les uvéites postérieures ; la plus fréquente étant due à la toxoplasmose.
Membrane épimaculaire et trou maculaire
Ce sont des pathologies de l’interface vitréorétinienne (Dystrophies rétiniennes, ou hérédo- dégénérescences rétiniennes
Ce sont des affections rétiniennes (- les dystrophies maculaires avec une atteinte prédominante sur les cônes. La plus fréquente est la maladie de Stargardt, de transmission autosomique récessive ;
- les rétinopathies pigmentaires, qui sont des dystrophies rétiniennes atteignant dans un premier temps les bâtonnets puis généralement les cônes dans un second temps. Il y a plus de 200 mutations décrites à ce jour. Les patients se plaignent d'abord d’une héméralopie (cécité nocturne), puis d’un rétrécissement du champ visuel, avant une baisse d’acuité visuelle.
Rétinopathie toxique aux antipaludéens de synthèse (APS)
Elle correspond à une atteinte maculaire bilatérale et irréversible. Les examens complémentaires pouvant être nécessaires au diagnostic sont un champ visuel central, un examen OCT, un cliché en autofluorescence et un électrorétinogramme multifocal. Étant une pathologie « dose-dépendante », elle peut apparaître après cinq ans de prise régulière et elle impose de pratiquer un dépistage annuel ou tous les six mois. L’altération d’un seul de ces examens fait envisager l’arrêt du traitement par APS, les lésions constituées étant irréversibles ; la décision de continuer ou non doit être prise avec l’interniste.Maculopathie aux inhibiteurs de MEK
Les inhibiteurs de MEK agissent sur des voies intracellulaires appelées voie MAPK. Ils sont de plus en plus utilisés en oncologie, notamment dans la prise en charge des mélanomes métastatiques. Les symptômes oculaires surviennent souvent de manière rapidement progressive. L’atteinte rétinienne la plus fréquente se traduit par l’apparition spontanée de plusieurs décollements séreux rétiniens (Maculopathie au « poppers »
La maculopathie au nitrite d’alkyle, ou « poppers », est une affection rare. La présentation clinique est caractéristique et associe dans les heures ou les jours suivant l’inhalation de la substance, une baisse d’acuité visuelle avec phosphènes et microscotome central. L’examen du fond d’œil est le plus souvent normal. L’OCT montre une atteinte des photorécepteurs maculaires. Il n’existe pas de traitement spécifique, et l’évolution se fait généralement vers une disparition des symptômes en quelques jours.POINTS FORTS À RETENIR
Une altération chronique de la fonction visuelle peut affecter la vision centrale (entraînant une baisse d’acuité visuelle) ou la vision périphérique (atteinte du champ visuel).
Les altérations de la fonction visuelle peuvent être liées à une pathologie ophtalmologique ou être d’origine neurologique (atteinte des voies visuelles).
Le diagnostic d’une altération de la fonction visuelle nécessite d’en préciser les caractéristiques (type, côté, ancienneté, évolutivité, symptômes associés), d’examiner l’œil et ses annexes, de rechercher des facteurs associés.
Les examens complémentaires sont à discuter au cas par cas, mais la tomographie rétinienne (OCT pour optical coherence tomography) et l’étude du champ visuel apportent des éléments clés pour localiser l’atteinte.
Altération chronique de la vision
L’étudiant doit considérer cette question portant sur l’altération chronique de la fonction visuelle comme une synthèse portant sur des pathologies ophtalmologiques déjà vues ailleurs. Néanmoins, la description des principales anomalies du champ visuel constitue un volet important et spécifique de cette question. La présentation particulière de cette question doit ainsi permettre à l’étudiant de préciser les orientations diagnostiques face à une baisse d’acuité visuelle progressive et de définir les examens ophtalmologiques ou généraux à demander dans ce contexte particulier. Le mode de raisonnement développé dans cette question est très proche de celui utilisé en clinique. Il est également particulièrement adapté aux questions des dossiers de l’ECN. Ce chapitre peut faire l’objet d’un dossier spécifique orienté sur le vieillissement. En effet, des défauts visuels s’observent chez les personnes âgées, par le biais de la cataracte, de la dégénérescence maculaire liée à l’âge... Par ailleurs, la présence d’un déficit visuel permet facilement de poursuivre le dossier par des questions sur la prise en charge du handicap. Des altérations de la fonction visuelle peuvent aussi s’observer dans des affections générales : neurologiques ou neurovasculaires (sclérose en plaques, accident vasculaire cérébral, tumeur...), diabète, etc.